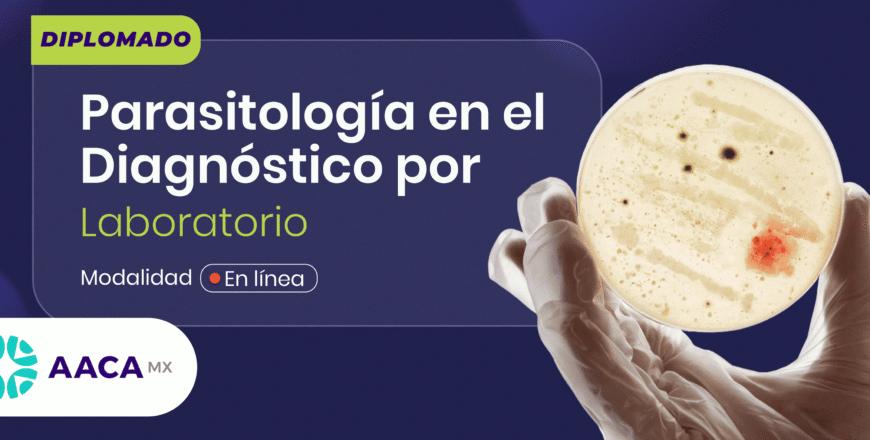
PORTADA AACA 01 (1) (2).png

Fecha de inicio del diplomado: 22 de Febrero 2026
OBJETIVOS DEL PROGRAMA
Capacitar al profesional del área biomédica y de laboratorio en el reconocimiento, análisis e interpretación de parásitos de importancia médica, zoonótica y ambiental, mediante técnicas actualizadas de diagnóstico aplicables en contextos clínicos, veterinarios y ambientales, con enfoque práctico y normativo para el contexto mexicano.
PERFIL DE EGRESO
El egresado será capaz de identificar, analizar y reportar parásitos de interés clínico, ambiental y zoonótico mediante técnicas actualizadas de diagnóstico parasitológico, con fundamentos científicos, éticos y normativos.
8 Módulos: Sesiones quincenales de 9:00 am – 1 pm (Hora de la Ciudad de México) – en google Meet.
CALENDARIO DE CLASES EN VIVO 